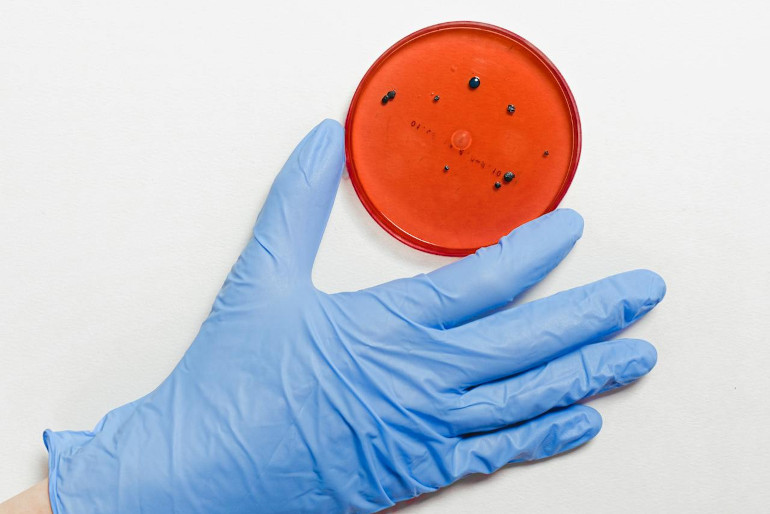

In this module students examine the structure and function of organisms at both the cellular and tissue levels in order to describe how they facilitate the efficient provision and removal of materials to and from all cells in organisms. They are introduced to and investigate biochemical processes, the study of microbiology, and the tools that scientists use in this field
This module builds on the knowledge of cell structure and function from Module 1 to how specialised cells, tissues, organs and systems operate to keep complex multicellular organisms alive. Organisms differ in their required inputs and how these are obtained, processed and transported around the organism.
Biodiversity is important to balance the Earth’s ecosystems. It can be affected slowly or quickly over time by natural selective pressures. In this module students investigate adaptations, broader structures, processes, and behaviours that assist organisms to survive in their specific habitats.
In this module students investigate the dynamic selection pressures that exist within ecosystems and how these result in evolution through natural selection. They also explore technologies used to develop the understanding of evolution and extend it to studying past ecosystems. Finally, students determine how understanding past and present ecosystems allows for predictions and better management of future ecosystems.
In this module students expand their knowledge of evolution by understanding the cellular processes involved in increasing genetic diversity. They investigate reproduction and inheritance patterns in both plants and animals as well as the role of DNA in polypeptide synthesis and the uses of technologies in the study of inheritance patterns. Students also learn about contemporary research and the work of geneticists across a variety of industries, as well as the effects on society and the environment through the application of genetic research.
In this module students learn about natural and human-induced causes and effects of genetic change, including mutations, environmental pressure and uses of biotechnology, and investigate how the processes of inheritance and evolution are applied. The impact of biotechnology on biological diversity is also explored in this module.
This module examines the treatment, prevention and control of infectious disease both locally and globally, and focuses on causes of infectious disease, responses to pathogens, and immunity. It includes study of the human immune system and its response to an infectious disease.
In this module students engage with the study of non-infectious disease and disorders, including their causes and effects on human health. They explore technologies and their uses in treating disease and disorders as well as the epidemiology of non-infectious disease in populations. Students learn the importance of understanding the multidisciplinary nature of science applications, as well as physiology and engineered solutions to problems related to the management of human disorders.
You can find more websites of interest relating to biology on our Resources page.